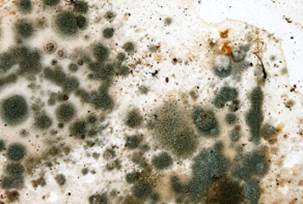

Neurotoxicité des moisissures
Validité, fiabilité et balivernes
Dr Paul R. Lees-Haley (ABPP)
La « neurotoxicité des moisissures » est une allégation de plus en plus courante dans les litiges relatifs aux préjudices personnels, bien qu’elle soit manifestement absente de la pratique médicale quotidienne. La controverse actuelle sur ce sujet est davantage alimentée par les avocats que par des désaccords scientifiques.
Les préjudices allégués sont divers et sont qualifiés de lésions cérébrales, d’encéphalopathies toxiques, de déficits cognitifs, de déficits neurocomportementaux, de troubles neuropsychologiques et de facettes du syndrome du bâtiment malsain ou de la maladie environnementale. Les symptômes présumés incluent des déficits de mémoire, des difficultés de concentration, des problèmes de langage et de raisonnement, de la fatigue mentale, de la dépression et de l’anxiété. L’année dernière, un article du Time Magazine mettait en garde : « Comme une sorte de fléau biblique, la moisissure toxique s’infiltre dans les maisons, les écoles et autres bâtiments à travers les États-Unis... Les plus grands gagnants sont les entreprises qui profitent de la frénésie engendrée par les moisissures. » (Hamilton 2001)
Prétendues preuves de la neurotoxicité des moisissures
La soi-disant « étude » la plus souvent citée comme preuve d’une altération neuropsychologique due à la neurotoxicité des moisissures n’est en réalité pas une étude scientifique et n’a pas été évaluée par des pairs au sens conventionnel du terme. La méthodologie était si mauvaise qu’elle ne sera jamais acceptée pour publication dans une revue scientifique de haute qualité et − à ce jour − n’a pas été publiée dans une revue scientifique, quelle qu’en soit la qualité. L’étude prétend avoir évalué des personnes exposées à la moisissure Stachybotrys chartarum, mais elle n’incluait ni groupe témoin ni batterie de tests standardisés administrés à tous les participants.
Aucune exposition toxique à d’autres moisissures n’a été étudiée. Les participants n’ont pas tous passé les mêmes tests, et l’auteur a témoigné qu’il n’a rapporté que les données de quelques tests qu’il a sélectionnés comme étant plus susceptibles de produire ce qu’il recherchait. Les résultats des tests neuropsychologiques des personnes étudiées étaient remarquables parce qu’ils étaient normaux et non altérés, mais les avocats et quelques-uns de leurs experts se réfèrent à ces résultats comme preuve de la neurotoxicité des moisissures. De plus, un examen des données utilisées pour préparer le manuscrit montre que le document ne reflétait pas fidèlement ce qui a été réellement fait.
Dans la seule autre étude pertinente faisant appel à des tests objectifs (étude évaluée par des pairs et publiée dans une revue) − par opposition aux rapports subjectifs −, la conclusion mentionne brièvement que les personnes « affectées » par les moisissures ont obtenu de meilleurs résultats dans les tests cognitifs que ceux appartenant au groupe témoin (Hodgson et coll., 1998).
Sudakin (1998) a constaté une augmentation des symptômes neurocomportementaux autodéclarés dans une étude de cas, mais il a mis en garde le lecteur que l’on avait rapporté à ces personnes les effets nocifs de l’exposition à des champignons toxigènes bien avant qu’elles se plaignent de signes subjectifs. Ces symptômes se sont considérablement améliorés après que les sujets eurent quitté le bâtiment. Plusieurs des sujets étudiés par Sudakin ont fait des demandes d’indemnisation.

« Neurotoxicité des moisissures »
(Image générée avec Midjourney par Horus)
Absence de symptomatologie cohérente
Malgré tout cela, il n’existe aucun schéma cohérent de symptômes ou de résultats de tests permettant de définir un diagnostic de « neurotoxicité des moisissures ». Il n’y a pas non plus de base scientifique pour affirmer que l’inhalation de spores de moisissures ou de mycotoxines dans les environnements domestiques et commerciaux provoque une altération neuropsychologique. Les effets neuropsychologiques de ces expositions sont inconnus.
Les soi-disant experts utilisent des arguments naïfs et vides, comme dire qu’ils ne peuvent penser à aucune autre raison pour laquelle une personne poursuivant pour des millions de dollars pourrait se plaindre de manière subjective et que la littérature scientifique ne réfute pas leurs opinions spéculatives. Ce sont là des arguments pseudoscientifiques.
Établir une preuve sans démonstration
Comme leur méthode est dépourvue de preuves objectives montrant que l’inhalation de moisissures ou de mycotoxines cause des lésions cérébrales, les soi-disant experts en matière de « moisissures toxiques » s’appuient fortement sur des rapports de symptômes subjectifs et sur des tests qui sont affectés par les biais de réponse inhérents aux contentieux. Leur approche est problématique pour au moins trois raisons :
· Comme nous l’avons mentionné ci-dessus, il n’existe aucun ensemble de plaintes permettant de circonscrire un syndrome neuropsychologique ou psychologique ou un trouble mental diagnostiquable associé à l’inhalation de mycotoxines ou à l’inhalation de spores de moisissures.
· Les experts en matière de litiges ignorent les recherches de plus en plus nombreuses qui démontrent que les patients en situation de litige se comportent différemment des autres personnes, ce qui affecte directement les examens d’experts sur leur état. Les plaignants décrivent souvent leurs antécédents antérieurs à leur exposition aux moisissures en des termes inhabituellement bénins et ne tiennent pas compte, dans une mesure invraisemblable, d’autres explications à leurs plaintes, telles que des facteurs de stress importants dans leur vie. Ils répondent plus fréquemment de façon anormale à des tests neuropsychologiques, même lorsqu’aucune personne ne prétend qu’ils ont des lésions cérébrales — ni leurs avocats, ni leurs médecins, ni les plaignants eux-mêmes. En d’autres termes, les artéfacts associés aux contentieux ont une incidence sur les résultats des tests neuropsychologiques. Les plaignants qui présentent des réclamations pour lésions cérébrales légères réagissent souvent aux tests psychologiques d’une manière plus altérée que les personnes ayant une lésion cérébrale grave attestée.
· Les résultats des tests sont contaminés par les biais découlant des litiges et ne reflètent pas véritablement l’ampleur du préjudice. Il est de plus en plus évident que les avocats et autres défenseurs associés à des actions en justice influencent suffisamment les plaignants de manière à entraîner des résultats trompeurs et erronés aux tests psychologiques et neuropsychologiques.
· Parmi les personnes étudiées, l’effort fourni par le patient pendant les tests neuropsychologiques a un effet plus important sur les résultats des tests que l’intensité de la lésion, même en incluant les lésions cérébrales graves (voir par exemple Green et coll., 2001).
Comment, à partir de symptômes bénins, on en vient à croire être affecté d’une psychopathologie
Des personnes vraiment perturbées se sont retrouvées, parfois à leur désavantage, impliquées dans ces affaires. Par exemple, les individus ayant des troubles somatoformes et des personnalités histrioniques ont tendance à être influençables et donc vulnérables aux zélotes et aux défenseurs qui leur disent qu’ils sont atteints de lésions cérébrales et condamnés à subir des déficits permanents causés par leur environnement toxique.
La plupart d’entre nous ignorent plus ou moins, ou remarquent et écartent les banals « symptômes de la vie » comme les douleurs passagères, la capacité variable de concentration, la fatigue temporaire, le stress ressenti ou l’incapacité de se rappeler toutes sortes d’informations telles qu’un mot ou un nom ou l’endroit où nous avons laissé quelque chose.
Cependant, lorsqu’un professionnel de la santé affirme qu’il s’agit de symptômes de neurotoxicité des moisissures, une personne crédule peut porter davantage attention à ces manifestations, s’alarmer et s’engager dans un cercle vicieux de surinterprétation de symptômes bénins, d’anxiété et voir se multiplier les symptômes causés par cette anxiété et devenir encore plus inquiète, parfois au point d’en devenir pratiquement obsédée. Ces ressentis devenant plus perceptibles et plus fréquents, il est donc facile de conclure qu’ils doivent avoir été causés par l’exposition aux moisissures.
Prévalence des psychopathologies chez les personnes considérées comme normales
Bien que la plupart d’entre nous ne pensent pas actuellement souffrir des effets d’une lésion cérébrale légère due à la moisissure ou à quoi que ce soit d’autre, les études empiriques ont montré à maintes reprises que des taux étonnamment élevés de symptômes de lésions cérébrales légères et de symptômes psychologiques sont courants dans la population adulte ainsi que chez les étudiants et les patients médicaux (par exemple, voir Dunn, Lees-Haley, Brown, Williams et English, 1995 ; Gouvier, Cubic, Jones, Brantley et Cutlip, 1992 ; Gouvier, Uddo-Crane et Brown, 1988 ; Fox, Lees-Haley, Earnest et Dolezal-Wood 1995a, 1995 b ; Lees-Haley et Brown, 1993).
De même, les études de prévalence montrent que les taux de troubles psychiatriques sont « plus élevés qu’on ne le pensait auparavant » (Kessler, McGonagle, Zhao, Nelson, Hughes, Eshleman, Wittchen et Kendler, 1994, p. 8 ; voir aussi Regier, Boyd, Burke, Rae, Myers, Kramer, Robins, George, Karno et Locke, 1988 ; et Robins, Helzer, Weissman, Orvascel, Gruenberg, Burke et Regier, 1984).
Ainsi, lorsque quelqu’un recherche une possible psychopathologie, elle n’est pas difficile à trouver puisqu’elles sont plus répandues que beaucoup de gens ne l’imaginent.
Les plaignants qui présentent des réclamations pour lésions cérébrales légères réagissent souvent aux tests psychologiques d’une manière plus altérée que les personnes ayant une lésion cérébrale grave attestée.
Le recours à des procédures diagnostiques sur une population aléatoire ou sans contentieux conduit à la détection de faux positifs et de pathologies réelles qui étaient silencieuses (non diagnostiquées) avant le test. Ainsi, il n’est pas surprenant que le test d’un groupe de plaignants mène à la découverte d’un préjudice apparent, sans qu’on puisse déterminer s’il était existant ou non avant l’objet de la plainte.
Des personnes moyennes, sans antécédents de lésion cérébrale, obtiennent des scores anormaux à plusieurs des tests d’une batterie de tests neuropsychologiques détaillés. Mais certains experts ignorent ces « taux normaux d’anomalie » et surinterprètent les résultats des plaignants comme une indication d’encéphalopathie toxique.
Moisissures
Enseigner aux témoins oculaires à voir des phénomènes invisibles
Dans des contextes ambigus tels que des arguments juridiques controversés sur notre connaissance de la neurotoxicité des moisissures, les influences psychologiques prennent une importance croissante pour déterminer ce qui est perçu comme réel. Les informations diffusées par les médias, les politiciens, les militants, les parties en litige, les experts et les avocats peuvent provoquer d’importantes réactions émotionnelles chez les personnes concernées. Une allégation peut être fausse, mais elle peut causer une réelle inquiétude et une authentique détresse émotionnelle à des personnes naïves si des affirmations trompeuses sont prises au sérieux.
Afin de contrecarrer un plaidoyer sans fondement, il est crucial d’intégrer de bonnes données scientifiques dans les arguments relatifs à la neurotoxicité des moisissures. Les parties intéressées encouragent la spéculation et font, d’une manière si catégorique, des allégations sans fondement, que nous sommes tentés de les croire pour des raisons illusoires. Les avocats et les cliniciens qui ne peuvent pas, ou ne veulent pas, utiliser les données scientifiques s’appuient en grande partie sur des techniques de propagande et d’influence sociale telles que :
· Preuve sociale : Si un avocat donne l’impression que plusieurs personnes crédibles ont conclu que les moisissures leur avaient causé des lésions cérébrales, il y a une tendance humaine naturelle à être d’accord, et à insinuer que vous manquez en quelque sorte de crédibilité si vous n’êtes pas d’accord. Identifier quelques personnes qui croient à une proposition et les encourager à s’exprimer publiquement, surtout de manière répétée, va donner l’impression qu’il y a beaucoup de gens qui viennent de découvrir quelque chose de fondé.
· Affirmations répétées : Le simple fait de répéter votre affirmation encore et encore donne l’impression qu’elle est vraie. Car après tout, comme chacun le sait, là où il y a de la fumée, il y doit y avoir du feu.
· Appels à l’autorité : Plus de gens seront convaincus si une ou plusieurs des personnes qui supportent une affirmation font autorité, par exemple, un expert ou une personnalité de la société civile. Parfois, les politiciens se laissent convaincre de partager une rhétorique non fondée, mais avantageuse politiquement. De plus, si un acteur populaire, une figure médiatique, un politicien ou un héros local en qui nous avons confiance donne son opinion, nous serons plus nombreux à le croire et à approuver cette perception de la réalité.
· Exemples frappants : Plus que des exemples quantitatifs ennuyeux, mais plus rigoureux, les études de cas dramatiques influencent souvent notre jugement. Présentée de manière à faire peur, une image de moisissure noire en plan rapproché peut amener l’observateur à conclure qu’une chose aussi sinistre doit causer le tort allégué.
En réponse aux critiques récentes de la pseudoscience, les arguments antiscientifiques sont en hausse. Les militants nous disent : « Nous ne pouvons attendre la science. Nous devons agir maintenant » et « les scientifiques ne veulent pas que nous agissions ! Combien de personnes doivent mourir avant que les accusés ne fassent ce qui est juste ? » Ironiquement, l’un de ces critiques a déclaré : « Nous ne pouvons pas attendre la science, nous devons agir sur la base de preuves ! »
Certes, nous prenons la plupart de nos décisions dans la vie sans d’abord mener une étude scientifique. Cependant, l’affirmation selon laquelle les spores de moisissure qui nous entourent tous les jours causent des lésions cérébrales est une question factuelle à laquelle on ne peut répondre qu’en examinant les données, et non par des réactions émotionnelles basées sur la spéculation, le sensationnalisme et les insinuations.
Différences entre les plaignants en litige et les personnes qui n’intentent pas de poursuite ; résolution des symptômes retardée
Les patients qui intentent un procès rapportent des symptômes plus intenses, plus fréquents et plus persistants que ceux qui ne sont pas en contentieux. Par exemple, un certain nombre d’études prospectives ont montré que les personnes qui souffrent d’une lésion cérébrale légère, mais en dehors de litige, se remettent généralement de leurs symptômes en quelques mois. (Barth, Alves, Ryan, Macciocchi, Rimel, Jane et Nelson, 1989 ; Dikmen, Ross, Machammer et Temkin, 1995 ; Dikmen, McLean et Temkin, 1986 ; Gronwall et Wrightson, 1974 ; Hugenholtz, Stuss, Stethem et Richard, 1988 ; Levin, Mattis, Ruff, Eisenberg, Marshall, Tabaddor, High et Frankowski, 1987).

« Neurotoxicité des moisissures »
(Image générée avec Midjourney par Horus)
Cependant, le rétablissement des patients en litige n’est généralement pas conforme aux attentes, car les plaintes comme les pertes de mémoire, les maux de tête, les étourdissements, les difficultés de concentration, la vision trouble, la photophobie, les bourdonnements d’oreilles, l’irritabilité, la fatigue, l’anxiété et la dépression (Organisation mondiale de la santé, 1978) continuent longtemps après la disparition normale de ces symptômes (Binder, Rohling et Larrabee, 1997).
De nombreuses études empiriques ont décrit des écarts entre les patients en litige et ceux qui ne font pas de demande d’indemnisation (voir, par exemple, Berry, Wetter et Youngjohn, 1995 ; Levin et coll., 1987 ; Youngjohn, Davis et Wolf, 1997).
Fee et Rutherford (1988) ont comparé la fréquence des symptômes rapportés par les patients souffrant de lésions cérébrales légères et faisant l’objet d’un litige à celle des patients ne faisant pas l’objet d’un litige. Après avoir estimé la gravité des problèmes de santé initiaux, les taux de signalement ont été évalués pour divers symptômes, dont les maux de tête, l’anxiété, l’irritabilité, les étourdissements, la dépression et l’insomnie. Lors du suivi, les patients en litige ont signalé près de deux fois plus de symptômes que les patients non en litige.
Les différences entre les symptômes déclarés par les plaignants et les non-plaignants ont été établies en ce qui concerne les lésions psychologiques et neuropsychologiques. Il a été constaté que les patients demandant une indemnisation déclaraient des symptômes psychologiques plus persistants que les patients souffrant de lésions similaires et ne demandant pas d’indemnisation.
Par exemple, Frueh, Smith, et Barker (1996) ont constaté que les anciens combattants cherchant à obtenir une invalidité liée au service pour syndrome de stress post-traumatique (SSPT) avaient des scores pathologiques nettement plus élevés, sur un large éventail de diagnostics psychologiques et sur les échelles de validité IPMM-2 (Inventaire de personnalité multiphasique du Minnesota-2), que les anciens combattants présentant le même tableau de SSPT sans demande d’indemnisation.
Pope, Butcher et Seelen (1993) ont constaté que les profils IPMM des patients dont l’évaluation de l’invalidité était en attente montraient davantage d’exagérations et de troubles. Leurs recherches ont également indiqué que les personnes qui sont réellement handicapées, mais qui n’attendent pas de décision sur leur handicap, ont tendance à produire des profils IPMM avec des résultats normaux. La demande d’indemnisation des patients a été citée comme l’un des obstacles les plus sérieux à la réussite du traitement du SSPT dans le système d’évaluation VA des anciens combattants (Richman, Frueh et Libert, 1994). Campbell et Tueth (1997) ont rapporté que le système d’indemnisation crée un effet dissuasif sur le désir de guérir et ont noté que « compenser en payant les individus pour la douleur et l’invalidité, en particulier à long terme, peut avoir de nombreuses conséquences négatives et, en fin de compte, peut desservir le patient » (p. 42).
Les professionnels de la santé ont noté des différences fondamentales entre les patients en contentieux et ceux qui ne le sont pas, et « se méfient de plus en plus de l’authenticité des symptômes présentés par les plaignants en raison de la grande disparité qui existe souvent entre les plaintes subjectives et les conclusions objectives » (Weissman, 1990, p.71). Les patients qui demandent une compensation financière peuvent se voir refuser un traitement parce qu’ils sont perçus comme résistant ou ne se conformant pas aux directives liées aux soins de psychothérapie et de réadaptation. Dans un contexte de litige ou de demande similaire d’indemnisation où les motivations, telles qu’un règlement, peuvent l’emporter sur l’amélioration de la santé, le traitement peut être reporté ou même réclamé à des fins juridiques.
Surestimation des fonctions neuropsychologiques précédant l’exposition aux moisissures
Des recherches récentes suggèrent que les patients en litige rapportent des symptômes plus intenses et de durée plus longue que les patients qui ne le sont pas. De plus, ces patients ont tendance à rapporter un fonctionnement psychologique et neuropsychologique antérieur aux blessures supérieur à celui des patients ordinaires (Lees-Haley, Williams et English, 1996 ; Lees-Haley, Williams, Zasler, Margulies, English et Stevens, 1997).
Par exemple, Lees-Haley et coll. (1997) ont demandé à deux groupes de se rappeler à quel point certains symptômes, comportements et aspects de la vie étaient problématiques dans le passé. Les patients qui cherchaient à obtenir une compensation se souvenaient de moins de problèmes de concentration, de mémoire, de fatigue, de dépression, d’anxiété, d’irritabilité, de maux de tête, de confusion, d’estime de soi, de couple ou de relation avec les enfants ainsi que de problèmes associés à l’école ou au travail.
Étant donné que la gravité apparente de la lésion ou de la perte fonctionnelle est essentiellement une comparaison entre les états antérieur et actuel, une différence plus tranchée entre les deux peut donner l’impression qu’une plus grande indemnisation est justifiée. Par conséquent, ne pas tenir compte de la tendance des plaignants à surestimer leurs fonctions antérieures à leurs problèmes neuropsychologiques induit en erreur les examinateurs judiciaires et les juges quant à la gravité de ces problèmes.
Exagération des symptômes et simulation
La simulation est définie comme la production intentionnelle de faux symptômes physiques ou psychologiques grossièrement exagérés, motivés par des raisons externes telles que le gain financier, l’obtention de médicaments, l’absentéisme au travail, l’évitement de poursuites pénales, etc. (Association américaine de psychiatrie, 1994).
Contrairement à ce que beaucoup d’entre nous croient à la lumière de notre expérience clinique, des études empiriques ont révélé que la simulation est courante dans les évaluations judiciaires. Cependant, les tribunaux ont été plus sages que les cliniciens et ont reconnu ce problème depuis longtemps. Les mentions de réclamations frauduleuses et de faux témoignages sont présentes, tout au long de l’histoire du droit, dans les cas publiés et les commentaires juridiques. Dans le plus ancien code de lois connues, le Code de Hammurabi, les participants du système juridique s’attaquaient déjà au problème (la politique de Hammurabi était de tuer les témoins qui avaient fait un faux témoignage) (Johns, 2000). En effet, le problème du faux témoignage est la première question abordée avec chaque témoin à qui on demande : « jurez-vous de dire la vérité, toute la vérité, et rien que la vérité… ? »

Affiche du film parodique Liar Liar (Menteur menteur) avec Jim Carrey dans le rôle d’un avocat (lawyer) particulièrement exubérant et menteur (liar).
Les patients qui cherchent à obtenir une indemnisation sont davantage portés à produire des rapports faux ou exagérés sur leurs symptômes que ceux qui cherchent à obtenir un traitement. Les estimations publiées de la proportion de plaignants simulant des déficits psychologiques varient de 1 % (Keiser, 1968) à plus de 50 % (Miller et Cartlidge, 1972). Dans les cas de lésions corporelles, la simulation de déficits cognitifs a été estimée à 64 % (Heaton, Smith, Lehman et Vogt, 1978) et 47 % de l’indemnisation des accidents du travail pourraient impliquer des simulations (Youngjohn, 1991).
Une autre étude a estimé que le pourcentage de déficits de mémoire simulés chez les patients présentant un syndrome post-commotion persistant se situait entre 33 et 60 % (Greiffenstein, Baker et Gola, 1994). Ces études sont pertinentes parce que les plaintes déposées par ces personnes après leur commotion cérébrale sont très semblables à celles qui ont pour cause les « moisissures toxiques ». Et dans les deux cas, les plaignants semblent souvent énoncer des réponses biaisées liées au litige.
Les recherches de Binder (1993) montrent que 33 % des sujets atteints de lésions cérébrales légères pour lesquelles ils cherchent à se faire indemniser ont simulé un déficit cognitif lors de tests psychométriques. Les examinateurs judiciaires devraient envisager et exclure la possibilité que les symptômes rapportés et les résultats des tests aient pour origine 1)de fausses déclarations des plaignants pendant leurs entretiens et 2) l’exagération des symptômes dans les questionnaires ou les tests d’autoévaluations. En médecine légale, il est devenu courant de soupçonner la simulation dans les diagnostics différentiels.
Facilité de simuler un trouble psychiatrique
Certains psychologues et psychiatres affirment que les plaignants sont incapables de simuler des troubles mentaux ou des déficits neuropsychologiques sans être détectés par les experts en psychologie. Par contre, l’idée que des personnes inexpérimentées peuvent simuler avec succès des symptômes psychologiques et neuropsychologiques, lorsqu’elles reçoivent un minimum d’informations sur les troubles, est largement soutenue. (par exemple : Albert, Fox et Kahn, 1980 ; Faust, Hart et Guilmette, 1988 ; Lamb, Berry, Wetter et Baer, 1994 ; Rogers, Bagby et Chakraborty, 1993 ; Rogers, Ornduff et Sewell, 1993 ; Wetter, Baer, Berry, Robison et Sumpter, 1993).
Ainsi :
· Une étude antérieure a démontré l’aptitude des étudiants universitaires à simuler avec succès la schizophrénie au moyen du test de Rorschach (Albert et coll., 1980). Après avoir regardé un film de 25 minutes sur la schizophrénie, 72 % des étudiants universitaires ont réussi à simuler le trouble, comparativement à 46 % de ceux qui ne l’avaient pas regardé.
· Lors d’une autre enquête analogue, les participants à qui on a demandé de simuler un traumatisme crânien ont reçu des renseignements détaillés sur le type d’échelles de validité de l’IPMM-2 et comment ne pas se faire prendre. Les résultats ont montré que cette information a permis aux sujets de produire des profils cliniquement élevés dans les limites des échelles de validité (Lamb et coll., 1994).
· Des personnes qui n’ont reçu aucune information ont été en mesure de rapporter des symptômes similaires à ceux de véritables patients ayant des problèmes psychiatriques en répondant à certains types de questionnaires, tels que les listes énumératives de symptômes (Lees-Haley, 1989a, 1989b).
· D’autres recherches indiquent que les personnes sans formation sont capables de reproduire avec précision les symptômes et le ressenti du syndrome post-commotion (Mittenberg, DiGiulio, Perrin et Bass, 1992) ainsi que la dépression majeure, le trouble anxieux généralisé et le SSPT (Lees-Haley et Dunn, 1994).
Tous ces résultats montrant que des personnes ordinaires peuvent simuler une psychopathologie sans éveiller les soupçons sont un problème pour les examinateurs. Les informations relatives à certains troubles psychologiques et neuropsychologiques sont facilement accessibles pour un plaignant déterminé à mentir. Berry (1995) souligne que « les simulateurs peuvent se familiariser avec les symptômes psychiatriques par le biais de connaissances personnelles, de la lecture de volumes comme le Diagnostic and Statistical Manual of Mental Disorders IV DSM-IV (APA, 1994), de livres de psychiatrie, ou même par l’exposition à des sources non scientifiques comme des articles de magazines et des films sur des personnes atteintes de troubles mentaux » (p. 88).
Influence des avocats : comment ils « préparent » leur client aux évaluations psychologiques
L’influence des avocats constitue un autre facteur de confusion dans l’évaluation des patients engagés dans un litige. Bien que les experts en psychologie aient été lents à se rendre compte de l’ampleur du problème, la crainte de l’influence des avocats sur les examens n’est pas un concept nouveau dans le milieu juridique. En Californie, le problème est suffisamment important pour que le Code de procédure civile de la Californie n’autorise pas les avocats à participer aux évaluations psychologiques (voir CCCP 2032g).

Dans la décision Ragge c. MCA/Universal Studios 165 F. 605 (Cal. 1995), le juge fédéral a décidé qu’un tiers observateur ne devrait pas assister à l’évaluation et que le psychologue ne devrait pas être tenu de divulguer à l’avance quels tests seraient utilisés. De telles divulgations sont une invitation à la fraude.
Les avocats sont censés apprendre les faits de leurs clients et non pas les inventer. Mais, comme l’a fait remarquer Geoffrey Hazard, professeur de droit à l’Université de Pennsylvanie et membre de la commission sur l’éthique de l’American Bar Association (2000), « les avocats disent à leurs clients ce qu’ils doivent faire, indirectement… À quel point ils sont retors, à quel point ils sont rusés, cela varie. » (cité dans Dolan, 1994, p. A 17). Resnick note que « dans le cadre d’une poursuite pour dommage corporel, dès qu’une personne devient partie à un litige, [...] les efforts des avocats autant auprès du plaignant que du défendeur peuvent modifier l’attitude du patient et l’évolution de sa maladie » (1988, p. 88).
Les avocats influencent les données psychologiques de plusieurs manières. Ils conseillent aux clients comment répondre aux tests psychologiques, font des suggestions sur ce qu’il faut dire aux psychologues examinateurs et sur ce qu’il faut souligner, puis les incitent à ne pas divulguer certains renseignements importants. Les avocats peuvent suggérer à leurs clients de prendre des mesures qui influent sur les antécédents cliniques, par exemple : leur dire que cela « serait mieux » s’ils ne retournaient pas au travail, et que « cela pourrait valoir la peine de consulter un médecin chaque semaine » (Rosen, 1995, p. 84).
Certains avocats fournissent aux plaignants des informations non seulement sur les symptômes, mais aussi sur les tests psychologiques permettant de détecter la simulation (voir, par exemple, Baer, Wetter et Berry, 1995 ; Dolan, 1994 ; Legate, 1996 ; Lees-Haley, 1997 ; Platt et Husband, 1986 ; Rosen, 1995 ; Taylor, Harp et Elliott, 1992 ; Wetter et Corrigan, 1995 ; Youngjohn, 1995).
Comme l’a fait remarquer Youngjohn (1995), « les psychologues et les neuropsychologues qui effectuent des examens médico-légaux supposent généralement que leurs patients n’ont pas été préparés ou “instruits” avant l’examen » (p. 282). Baer, Wetter et Berry (1995) notent que « compte tenu de la probabilité croissante que la supervision des personnes qui passent le test puisse se dérouler dans divers contextes, il est important que les cliniciens en comprennent les effets » (p. 198).
Wetter et Corrigan (1995) ont fourni d’autres preuves de la volonté des avocats à s’immiscer dans l’évaluation psychologique. Ces chercheurs ont mené une enquête dans laquelle 63 % des avocats interrogés estiment qu’ils doivent fournir aux plaignants des informations sur les mesures de validité des tests psychologiques (47 % des avocats interrogés ont déclaré qu’ils doivent « toujours ou habituellement » fournir ces informations à leur client avant le test et 16 % ont déclaré qu’ils doivent « parfois » le faire). Parmi les 63 % d’avocats qui estimaient devoir fournir de telles informations, 42 % ont déclaré qu’ils doivent fournir « autant d’informations que possible » et 42 % ont déclaré qu’ils estiment devoir fournir une « quantité modérée d’informations », pour un total de 84 %.
Youngjohn (1995) a rapporté les propos d’un avocat qui a soutenu que le fait de ne pas conseiller un plaignant avant le test psychologique est légalement une faute professionnelle. D’autres recherches menées auprès de plaignants dans des litiges de préjudices corporels confirment l’existence de la supervision, particulièrement dans les cas liés aux séquelles psychologiques d’événements traumatiques (Rosen, 1995).
Non, non ! Mon avocat ne m’a rien dit !
Lorsqu’on demande aux plaignants qui subissent des évaluations neuropsychologiques si quelqu’un leur a parlé de leur évaluation, ils répondent presque toujours non, mais ajoutent souvent que leur avocat leur a dit de dire la vérité. Cependant, plus tard dans l’évaluation, il est fréquent qu’on réponde à une question avec des variantes de « Mon avocat m’a dit que je n’avais pas à répondre à ça ». Dans certaines évaluations, cette réponse est donnée à plusieurs reprises, malgré le démenti d’avoir parlé à qui que ce soit avant l’évaluation.
Étant donné que les communications entre l’avocat et son client sont privilégiées, sauf si l’avocat et le plaignant s’entendent pour commettre une fraude, par exemple, si l’avocat aide un plaignant simulateur, les psychologues n’enquêtent habituellement pas directement sur la supervision de l’avocat pendant l’entrevue. Cependant, des commentaires spontanés comme ceux-ci indiquent que de nombreux plaignants sont conseillés sur la manière de se conduire dans une évaluation psychologique. Larry Cohen, avocat à la faculté de droit de l’Université du Michigan (communication personnelle, mars 1997), a signalé que certains avocats considèrent que le fait de demander au client de nier que la supervision ait eu lieu fait partie du privilège « avocat client ».

(Image par Mohamed Hassan de Pixabay)
Bien que les avocats hésitent à discuter de communications privilégiées avec des clients particuliers, ils partagent publiquement des renseignements pertinents dans le cadre du cours de formation juridique continue. Prenons par exemple le conseil donné lors d’une réunion nationale d’avocats, au cours de laquelle il a été conseillé aux participants de négocier avec les psychologues retenus « quelle sorte d’histoire ils souhaitent adopter ». (Bureau des affaires nationales, 1994, p. 52). Une avocate présente à cette conférence a dit qu’elle s’entretient avec des psychologues avant leurs évaluations et « je leur dis quels domaines je ne veux pas qu’ils explorent » (p. 52).
Dans le cadre d’un autre programme de formation juridique continue, on a enseigné aux avocats comment préparer les clients pour leurs évaluations indépendantes (EI) (Legate, 1996). Dans ce cours, on leur a déconseillé d’envoyer leurs clients à des examens indépendants sans préparation préalable par un avocat. Ils ont été invités à examiner et à « clarifier » les symptômes du client avant l’EI, et on leur a conseillé de ne pas présumer que le client non préparé serait cohérent. L’une des suggestions était « d’envisager la création d’une liste des symptômes que vous examinerez régulièrement avec votre client » (Legate, 1996, p. 5). Les plaignants ont-ils vraiment besoin d’avocats pour leur dire où ça fait mal ? Un enfant de deux ans peut vous le dire. Les avocats pensent-ils qu’en l’absence de leur assistance, les personnes qui souffrent beaucoup ne s’en rendent pas compte et oublient qu’elles souffrent ?
Dans une revue juridique largement diffusée, Taylor, Harp et Elliott (1992) ont publié un article sur la « préparation » du plaignant souffrant de lésions cérébrales légères. Ces avocats suggèrent de « prendre des mesures pour améliorer la capacité du client à se souvenir des faits essentiels » (p. 67). Ils recommandent que « l’avocat commence à préparer le témoignage du plaignant dès le début du procès » et fournissent une liste d’étapes à suivre avant les dépositions et le procès (p. 68). Notant que les clients atteints de lésions cérébrales « ont tendance à être un peu mal à l’aise avec le fait de témoigner [quelqu’un est-il à l’aise ?] », ils suggèrent que « les avocats doivent prendre grand soin de les préparer à témoigner » (p. 68). Ils recommandent de fournir des « instructions concernant la présentation, le comportement et l’habillement » lors du témoignage. Il est difficile d’imaginer qu’il n’y a aucun effet sur la perception d’un plaignant après une exposition prolongée auprès d’un avocat persuasif qui a reformulé à maintes reprises, dans un langage convaincant, les données d’un point de vue particulier du plaideur.
Si les avocats se donnent autant de mal pour préparer un client en vue d’une déposition ou d’un procès, on peut supposer qu’ils donnent des conseils semblables avant les examens médicaux et psychologiques qui pourraient avoir des répercussions considérables sur la validité du litige. Des directives – comme des instructions sur le comportement, la présentation, l’habillement et la mémoire – peuvent toutes avoir une incidence sur l’examen de l’état mental par l’expert en psychologie. Un plaignant histrionique, hypocondriaque ou menteur, bénéficiant de l’encadrement proposé dans cet article, pourrait apprendre à se comporter d’une manière trompeuse. Les effets de ces instructions sur un patient borderline ou délirant sont imprévisibles, mais préoccupants.
Influence des professionnels de la santé
· Modification du comportement du plaignant
Les experts en psychologie peuvent également altérer les données dans les litiges en matière de préjudices corporels. Par exemple, dans l’affaire non publiée de Lailhengue c. Mobil (Civil Action No. 90-4425, United States District Court for the Eastern District of Louisiana), un psychiatre a interrogé les plaignants en présence d’un avocat, puis leur a remis des copies des critères diagnostiques du Diagnostic and Statistical Manual of Mental Disorders (DSM) afin qu’ils les examinent, avant une deuxième entrevue, pour déterminer s’ils souffrent du syndrome de stress post-traumatique.
Dans une autre affaire non publiée dont le tribunal a demandé une non-divulgation publique, un psychologue assez éminent et un avocat se sont présentés devant un auditoire de plaignants alors que le psychologue décrivait les symptômes du syndrome de stress post-traumatique, immédiatement après quoi les plaignants ont été soumis à une évaluation de syndrome de stress post-traumatique de l’IPMM sans échelle de validité correspondante.
Même les plaignants honnêtes peuvent être amenés à grossir involontairement des plaintes existantes ou à en découvrir de nouvelles. Des examens physiques et psychologiques répétés effectués par des professionnels de la santé peuvent avoir ces effets inattendus. Comme l’a souligné Lishman (1986, p. 463), « la répétition des symptômes devant divers auditoires, certains encourageants, d’autres sceptiques, n’aident pas le patient à comprendre clairement ce qu’il éprouve réellement ».
Platt et Husband (1986) ont observé :
« Lorsque le patient ou plaignant arrive au cabinet du clinicien, il a souvent consulté non seulement un avocat, mais aussi de nombreux professionnels de la santé et des domaines connexes. Les patients peuvent ainsi percevoir des indices de la part de leurs avocats ou des professionnels qui les traitent quant aux symptômes qu’ils pourraient être censés présenter. Les questions posées et les messages communiqués par ces professionnels sur l’état physique et mental du patient peuvent avoir pour effet d’alerter secrètement ou même ouvertement le patient sur des symptômes supplémentaires qu’il n’avait pas signalés ou sur lesquels il n’avait pas insisté lors des évaluations antérieures, et de renforcer potentiellement les symptômes existants » (p. 35).
Ces études ont des implications importantes pour les examinateurs. Les croyances préconçues et les attentes antérieures peuvent aussi influencer le comportement d’une personne de manière qu’elle confirme les attentes des examinateurs (voir, par exemple, Snyder et Thomsen, 1988). La collecte et l’interprétation des données peuvent toutes deux être influencées par ces idées préconçues.
Par exemple, les cliniciens convaincus que l’exposition aux moisissures cause des déficits cognitifs peuvent, par inadvertance ou intentionnellement, communiquer leurs attentes aux patients, renforçant ainsi leurs auto-évaluations. À leur tour, les plaignants minimisent souvent les données relatives aux autres explications possibles des déficits (par exemple : la consommation déclarée de drogues et d’alcool et les facteurs de stress importants), augmentant ainsi l’importance des facteurs causaux jugés pertinents par les évaluateurs et les avocats.
L’hypothèse selon laquelle les problèmes de santé des patients ont été causés par des facteurs identifiés dans les plaintes déposées devant la justice peut devenir une prophétie autoréalisatrice dans laquelle les relations entre la cause présumée et les déficits sont perçues là où elles n’existent pas. (Pour une discussion sur la prophétie autoréalisatrice, voir Rosenthal et Jacobson, 1968).
· Influence des idées préconçues sur le jugement des examinateurs
Il est important de tenir compte des attentes des experts en matière d’évaluation, car elles peuvent avoir d’importants effets imprévus. Il existe une documentation abondante et croissante sur la nature et les conséquences des attentes des cliniciens en matière d’évaluation psychologique (voir, par exemple, Arkes, 1981 ; Blank, 1993 ; Chapman et Chapman, 1967 ; 1969 ; Dawes, 1994 ; Golding et Rorer, 1972 ; Salovey et Turk, 1991; Smith, 1988 ; Snyder, 1981 ; Snyder et Thomsen, 1988 ; Starr et Katkin, 1969 ; Turk et Salovey, 1988).
Par exemple, Temerlin (1968) a montré comment les attentes peuvent influencer le jugement des évaluateurs en milieu clinique. Avant d’écouter l’enregistrement d’une entrevue anodine avec un homme normal, les psychiatres ont entendu un collègue prestigieux qualifier la personne de malade mental. Même si l’entrevue n’a révélé aucun signe de psychopathologie, 60 % des psychiatres ont jugé l’homme psychotique et les 40 % restants ont diagnostiqué chez lui un trouble névrotique ou un trouble du caractère. Par contre, en l’absence « d’attente diagnostique » [associée à un collègue qui le qualifie de malade mental…], aucun psychiatre n’a qualifié cet homme normal de psychotique.
Dans une étude connexe, les cliniciens qui s’attendaient à observer un « patient » ont jugé la personne plus perturbée que les cliniciens qui s’attendaient à observer un « candidat à un emploi » (Langer et Abelson, 1974), sur la base de données par ailleurs identiques.
Tactiques pseudoscientifiques des experts
Enfin, les tactiques intellectuellement fallacieuses de certains experts dans les affaires de moisissures méritent d’être dénoncées pour ce qu’elles sont. Au lieu de s’appuyer sur des faits et la raison, ils utilisent des arguments pseudoscientifiques. Dans un cas, un expert a qualifié les opinions des sceptiques sur les allégations de neurotoxicité des moisissures de tactiques de l’« industrie du tabac » lorsqu’il ne pouvait réfuter les critiques avec des preuves et de la logique. Il a donc affirmé que les experts défendant l’accusé savaient en fait que les moisissures sont dommageables, mais voulaient cacher ce fait.
Certains experts de la partie prenante utilisent un langage alarmiste qui est plus susceptible de causer de la détresse émotionnelle chez le plaignant qui le prend au sérieux, bien que les effets réels des moisissures demeurent inconnus.
La présence sur Internet
De nombreux plaignants effectuent des recherches sur Internet qui les exposent à des revendications et des opinions de fiabilité et de validité très variables. Au moment d’écrire ces lignes (décembre 2002), une recherche sur Google avec l’expression « toxic mold » (moisissure toxique) donnait environ 36 000 liens (Note du traducteur : 71 M en 2023). En mars 2002, la liste était complétée avec un lien parrainé par le « Personal Injury LawyerShop » et intitulé « Découvrez les effets indésirables des moisissures toxiques ! », qui mène au « Toxic Mold InfoCenter », un site proposant « des informations sur les moisissures toxiques et un accès à des avocats spécialisés dans les litiges relatifs aux moisissures ». Au cours du même mois, le site Web « Docteur Fungus » présentait une personne qui intentait une poursuite de 65 millions de dollars. (Note de la rédaction : en 2023, plusieurs des sites Web mentionnés dans cette section sont maintenant inaccessibles.)

Aspergillus. (Crédit image : Kateryna Kon)
Le site Web « Toxic Mold and Tort News Online Safety, Prevention, and Information » déclarait : « Le site Web Toxic Mold est un guide complet d’information sur les moisissures, les moisissures toxiques, la sécurité et la prévention. Notre site fournit également d’importantes informations, notamment sur les droits garantis par la loi, aux personnes affectées par les moisissures toxiques à la maison, au travail ou ailleurs. » Ses paragraphes introductifs sur les « dangers potentiellement mortels » et les droits garantis par la loi sont suivis de résumés de quatre poursuites pour des moisissures dans lesquels les plaignants ont remporté plus d’un million de dollars.
La « Mold Source » contenait une liste d’experts médicaux et juridiques accompagnée de la déclaration suivante :
« Les professionnels suivants se sont érigés en tant qu’experts grâce à leur dévouement, leur engagement et leur très grande préoccupation pour l’humanité. Ce sont les meilleurs que le monde peut offrir à “nous”, les contaminés par les moisissures. Collectivement, ils sont au fait de la majorité des connaissances sur les moisissures et les maladies liées aux empoisonnements fongiques. Si le savoir c’est le pouvoir, alors ma prière en vous fournissant cette liste est de vous donner le “pouvoir” de faire une différence dans votre vie ou dans la vie de vos proches “exposés”. »
La liste comprenait le Dr William Rae, et plusieurs des principaux promoteurs du diagnostic bidon de « polysensibilité chimique ».
La page d’accueil du « Toxic Mold Survivors Information and Support Group » indiquait :
« Empoisonné par des moisissures toxiques ?
Stachybotrys, Aspergillus et Penicillium.
Les effets négatifs potentiels sur la santé comprennent : allergies et asthme allergique, rhinite allergique/sinusite, conjonctivite allergique, cancer, mycotoxicose, aspergillose, pneumopathie d’hypersensibilité, encéphalopathie neurotoxique, maux de tête, problèmes de mémoire et de langage, fatigue, malaise, vertige, étourdissements, dépression, sensation de brûlure à la gorge (laryngite), toux irritante, saignements de nez, tremblements, tachycardie (rythme cardiaque rapide), essoufflement à l’effort, oppression thoracique, respiration sifflante (bronchite et pneumopathie), dommages aux cils des voies respiratoires (altération de la protection des voies respiratoires), saignements des poumons (hémoptysie), immunotoxicité (incidence accrue des infections), dermotoxicité (dermatite, éruption cutanée), perte de cheveux, entérotoxicité (nausées, vomissements, diarrhée, douleur abdominale de type vésiculaire).
Toxiques pour le foie, le cerveau, les reins et le cœur, et en cas d’exposition chronique, les moisissures sont de puissants cancérogènes pour le foie.
La liste des effets néfastes sur la santé se poursuit… alors que les personnes empoisonnées essaient de survivre après avoir été exposées à des moisissures toxiques. »
Bien qu’il s’agisse apparemment d’un site Web pour un groupe de soutien, le contentieux semble constituer un intérêt majeur pour ces « survivants ». Par exemple, la page d’accueil fournit dans les liens vers :
· « Litigation » (contentieux) ;
· un article intitulé « Moisissures toxiques : le prochain amiante ? » par Sylvia Hsieh (Lawyers Weekly USA) ;
· les sites Web d’avocats et de témoins experts qui témoignent dans des litiges en matière de responsabilité délictuelle toxique.
Conclusion
Les avocats spécialisés en responsabilité civile toxique et une poignée d’experts qu’ils privilégient aimeraient vous faire croire que les « moisissures toxiques » handicapent les gens dans des proportions épidémiques en leur causant des dommages cognitifs. Pour que cela soit exact, il faudrait que la majorité écrasante des médecins, des toxicologues et des professionnels de la santé mentale qui ont étudié cette question se trompent complètement et que les médecins dans la pratique quotidienne aient raté ce diagnostic. Si un problème existe, on doute qu’il soit courant.
Un expert a estimé qu’il existe près de 100 000 espèces reconnues de champignons (Terr, 2001). Étant donné le nombre d’expositions possibles, dans des circonstances environnementales différentes, avec des personnes ayant des conditions mentales et physiques très variables, on peut spéculer et dire n’importe quoi. Mais la spéculation n’est pas une preuve.
Le débat sur la neurotoxicité des moisissures ne porte pas seulement sur les soins de santé et la science : l’argent et les litiges sont au cœur des communications des promoteurs de la toxicité des moisissures. Comme l’a fait remarquer Paul Scroggins (2002), un ingénieur en environnement de l’Environmental Protection Agency des États-Unis, « moisissures toxiques » est une expression qui se vend bien.
La campagne menée pour convaincre les gens des dangers des « moisissures toxiques » n’est pas seulement un exemple amusant de folie dans la société moderne. Les gens qui contournent les preuves scientifiques et s’engagent dans la diffusion de la polémique sur les « moisissures toxiques » ne font pas des actions sans conséquence. S’il s’avère que ces expositions sont inoffensives sur le plan neuropsychologique, les déclarations hystériques et les alarmes non fondées des avocats, des médecins et autres « experts » auront néanmoins porté préjudice à de nombreuses victimes. Qui sera tenu responsable de leur douleur, de leur souffrance ou de leur détresse émotionnelle après qu’on leur ait dit qu’ils allaient mourir ou être définitivement atteints de dommages cérébraux permanents ?
D’autre part, si nous découvrons des preuves de la causalité des déficits neuropsychologiques dans ce domaine, les résultats devraient être largement présentés de la manière la plus utile pour les patients concernés, et non pas sous forme d’hyperbole sensationnaliste. L’exploration des effets de l’inhalation de mycotoxines et de spores de moisissures devrait être réalisée par des études scientifiques de haute qualité et bien contrôlées, et non par des spéculations dans des contextes conflictuels.
Lectures complémentaires
· Les risques à la santé associés à la présence de moisissures en milieu intérieur - Document synthèse, Institut national de santé publique du Québec (2002).
· Brandt M. and others. Mold prevention strategies and possible health effects in the aftermath of hurricanes and major floods. MMWR 55(RR08):1-27, 2006.
· Centers for Disease Control and Prevention, Faits de base sur les moisissures et l’humidité (consulté en avril 2023).
Références
Les références à cet article se trouvent à la fin de l'article original en anglais : https://quackwatch.org/related/toxicmold/
Dernière mise à jour le 22 décembre 2023.
Source: Quackwatch